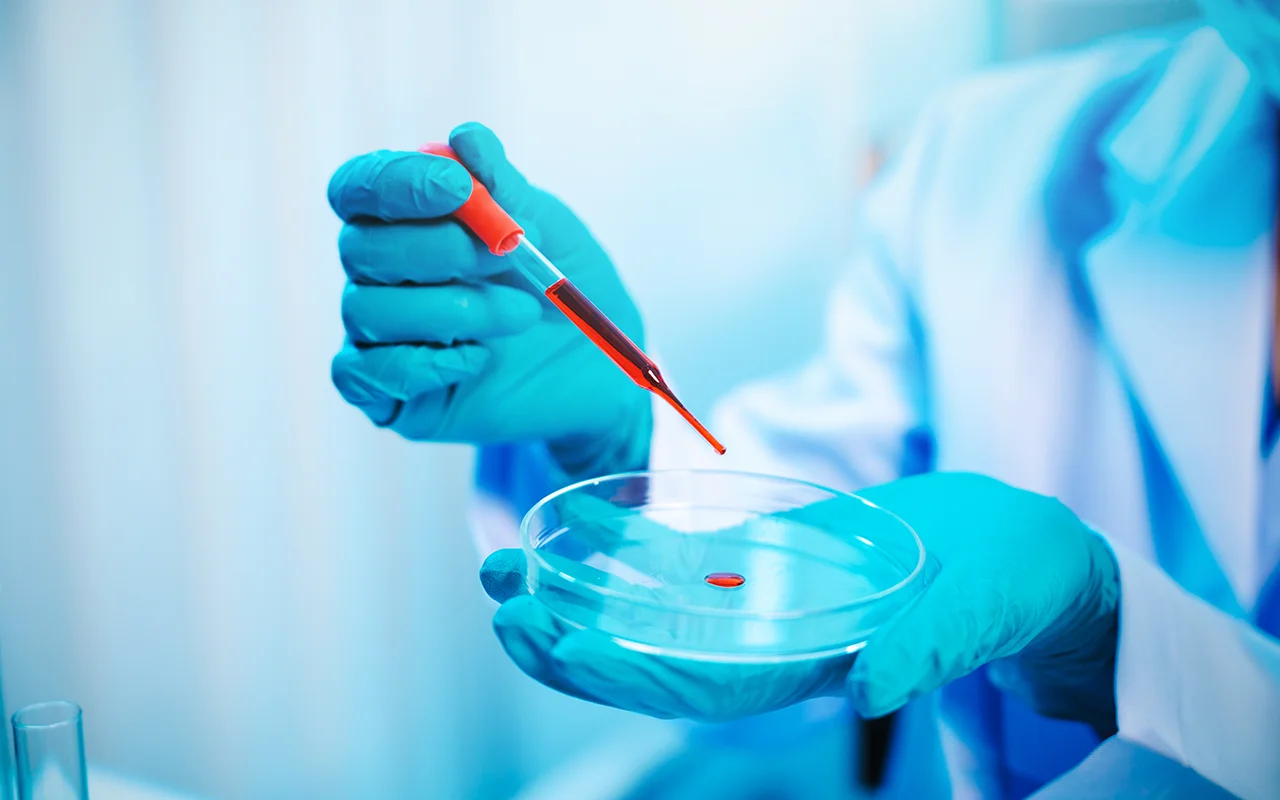
Microbiology & Parasitology studies Image

El Gouna Hospital provides comprehensive imaging facilities, including the most advanced CT scanner, ultrasound, coloured echo and Doppler machines, stationary and portable X-rays, and diagnostic GI endoscopy. The Laboratory provides blood, immunological, hormonal, and serological tests and Covid-19 tests
en
USD


Laboratory & Scans
- Home/
- The Town/
- Facilities/
- Healthcare/
- Laboratory & Scans
Get results fast with the most advanced scanning facilities and an on-site lab providing the whole spectrum of tests

Covid-19 Tests
PCR, antibody and antigen tests with the result after 30 minutes, ID-Now tests with results after two hours.

Blood, immunological, hormonal and serological tests

Histopathology Studies
Microbiology & Parasitology studies

Tumor Markers

Diagnostic GIT endoscopy

Ultrasonography

Colored Echo

Doppler

Stationary and Portable Conventional X-RAY

Open Magnetic Resonance Imaging Unit (open MRI)

New Multi-Slice CT Hi-Speed Unit
A computerised tomography (CT) scan uses X-rays and a computer to create detailed images of the inside of the body.
They're carried out by specially trained operators called radiographers and can be done while you're staying in the hospital or during a short visit.
CT scans can be used to diagnose conditions and guide further tests or treatment.

Alpha ST Mammography Unit
High-quality, state-of-the-art digital mammography technology is available at El Gouna Hospital.
The technology produces four images of breast tissue so your doctor gets a much clearer picture of your breast health.
Usually, during a mammography appointment, the doctor also performs an ultrasound of the breast.

